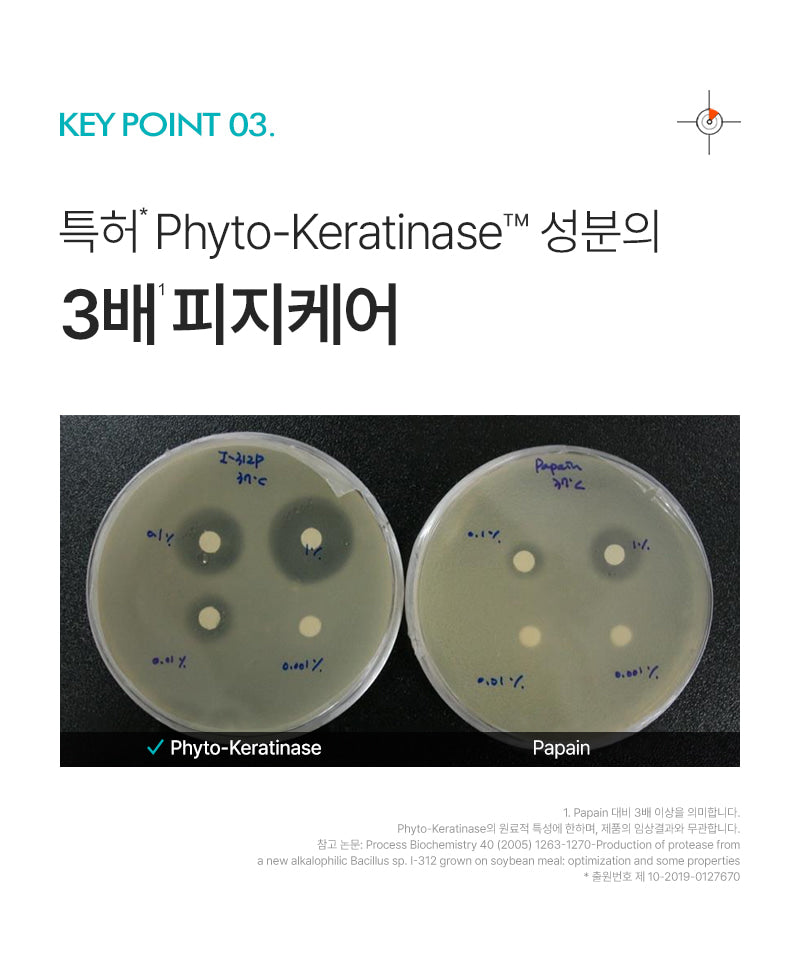

Description
For Concerns About Sagging Pores: Retinolagen™ Foam Cleanser
Ultra-Fine Bubbles for Deep Cleansing
The Retinolagen™ Foam Cleanser creates ultra-fine bubbles that break upon contact, effectively adhering to and lifting impurities from your pores. Even stubborn waste that cannot be addressed with a nose pack is gently but thoroughly removed, leaving your pores clean and refreshed.
Retinolagen Core Ingredient Combination
This unique formula combines natural oil capsules with the powerful Retinolagen core ingredient to penetrate deeply and cleanse inside your pores. Each application delivers 4,000 ppm of pore-cleansing capsules, ensuring your skin is left feeling smooth and clear.
Patented Formula for Enhanced Skin Elasticity
Patent 10-2686879: This exclusive wrinkle and pore improvement composition contains a potent blend of retinol and collagen. Together, these ingredients work synergistically to enhance skin elasticity, providing a more youthful and firm appearance.
Gentle yet Effective U-Shaped Pore Foam Cleanser
Designed to clean both the inside and outside of your pores simultaneously, this foam cleanser is low-irritation with a tested irritation index of 0.00. It’s ideal for sensitive skin, providing a deep cleanse without causing discomfort.
Key Features
-
Retinolagen Core Ingredient & Capsules
The combination of Retinolagen and vegan low-molecular collagen effectively cleans pores while also nourishing your skin. -
Moisture-Rich Alkaline Formula
Despite its slightly alkaline nature, the formula prevents skin tightness post-cleansing. Natural oil capsules help retain moisture, forming a protective barrier to keep your skin hydrated. -
Triple Sebum Care with Patented Phyto-Keratinase™
This patented ingredient offers three times the sebum control, ensuring your skin remains balanced and free from excess oil. -
No Artificial Colors or Fragrances
The formula is free from artificial colors and fragrances, making it safe for daily use.
How to Use
- Lather: Apply an appropriate amount of the foam cleanser onto wet hands and create a rich lather.
- Massage: Gently massage your entire face, focusing on areas with large pores, to lift and remove impurities.
- Deep Cleanse: For targeted care, use a brush on the T-zone and butterfly zone where pores tend to be larger.
Jojoba Seed Oil for Lasting Moisture
Enriched with jojoba seed oil, this cleanser forms a moisture barrier on the skin, ensuring your face remains soft and hydrated without any tightness after washing.

Rowan (verified owner) – Seattle, USA –
I tried this foam cleanser for a week. It has really tiny bubbles that clean well without feeling harsh. Pores look slightly better, but the scent is kinda faint which I wasn’t sure about at first. Packaging was okay; not fancy or anything. Happy overall with it though.
Liam – Melbourne, Australia –
I used the foam cleanser and liked how it removed dirt. My pores felt cleaner right away, though shipping took longer than I wanted.
Liam – Chicago, USA –
Used it a few times. Cleansed well but my pores feel slightly sticky afterwards. It worked okay for me, though I wanted something more effective on stubborn makeup.
Liam (verified owner) – Melbourne, Australia –
Used this cleanser for a week. My pores feel really clean after every use. The foam is light and gentle on my face. It actually helps with deep cleansing like they said.
Linh Nguyen from São Paulo, Brasil (verified owner) –
Meu rosto, agora sem impurezas. Adeus poros abertos! Sentimento fresco e leveza com essa espuma de limpeza retinoliana incrível.
Ngọc (verified owner) – Hai Phong, Vietnam –
Mình thấy sữa rửa mặt này khá ổn. Bọt rất nhẹ và dễ làm sạch sâu trong lỗ chân lông. Chỉ có điều, màu sản phẩm khác chút so với hình ảnh quảng cáo thôi.
Leonie Schneider from Berlin, Deutschland –
Ich kann wirklich bestätigen, dass der P.CALM Retinolagen Ampoule Shot Foam Cleanser ein kleines Wunder ist. Meine poröse Haut hat sich in nur wenigen Anwendungen erheblich verbessert. Die feinen Bläschen fühlen sich wunderbar an und reinigen tiefgründig – so erfrischend! Jetzt haben meine Poren mehr Luft zum Atmen.
Jordan Rix from Toronto, Canada –
After just one week with P.CALM, I’m thrilled! My pores appear tighter, and there’s a glow that wasn’t there before. Worth every penny!
Chandra Firth from Vancouver –
Using this ampoule has turned my nightly routine into a rejuvenating ritual. The gentle bubbles envelop my face, lifting dirt and tiredness seamlessly. I’ve noticed fewer visible pores; an elixir for all who’ve lost confidence due to age.
علي شمس الدين from اسطنبول, تركيا –
بينما جربت العديد من منتجات العناية بالبشرة، تركني مُنظف Retinolagen الشعور بالدهشة والسرور في آن واحد. تركيبته الفريدة تمنح تجربة فاخرة تجمع بين الاسترخاء والتنظيف المتعمق. الإحساس عندما تتكون فقاعات دقيقة ثم تختفي حين الاتصال ببشرتك يعكس دقة وفنية رائعة للمنتج. يستخدم كمّا لافتًا يُسهّل تنقية مسام البشرة المرهقة خلال عدة أيام فقط، وقد لمست تحولاً ملحوظًا وثبات بيِّن منذ استخدامي له!
Cassidy Aldrich from New York City, USA (verified owner) –
In the bustling streets of Manhattan, this cleanser surprised me. Its foamy embrace clears away life’s grime—my skin breathes again! Love it!
Amara Patel from New Delhi, India –
Diving into my skincare journey has led me to embrace the P.CALM Retinolagen Ampoule Shot Foam Cleanser, a delightful ally in managing the everyday grind of urban pollution on my skin. Surrendering my worries over clogged pores became effortless as those magical ultra-fine bubbles descended like a soft rain across my face, releasing impurities I once believed were eternal guests. The combined artistry of natural oil capsules and potent retinol felt less like an ordinary cleanse and more akin to unveiling buried treasure from beneath layers of dirt accumulated from roaming New Delhi’s bustling streets. Post-use, my skin reflects renewed vigor and remarkable elasticity that speaks volumes – or should I say whispers contentedly – about its efficacy! It’s rare for any product to deliver results while also catering to sensitive needs; this one manages beautifully.
Emma from Seattle, USA (verified owner) –
I’ve been using the P.CALM Retinolagen Ampoule Shot Foam Cleanser for a few weeks now, and I am genuinely impressed. The ultra-fine bubbles work wonders in deep cleansing my pores without feeling harsh. With each application, it delivers an impressive 4,000 ppm of pore-cleansing capsules that helped remove impurities I didn’t even know were there. My skin feels smoother and noticeably brighter after use. Plus, the patented formula improves elasticity – I’ve started to notice less sagging around my cheeks! Definitely a must-try if you’re looking for effective cleansing.